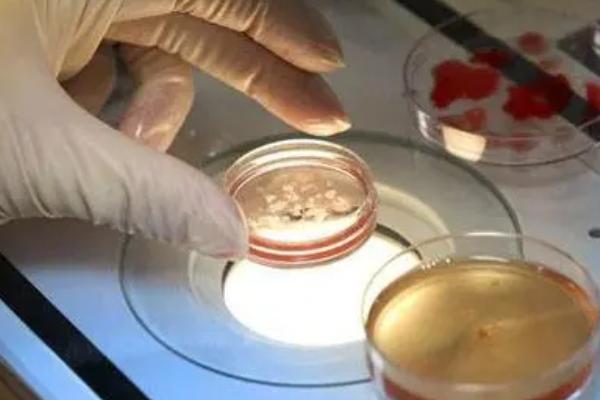
美国试管婴儿技术和国内三甲医院相比，哪个更好

更新时间:2023-11-18
试管婴儿技术是一种辅助生育技术,旨在帮助那些因不孕或其他生殖问题无法自然怀孕的夫妇实现生育愿望。美国和国内都有着发达的医疗体系,但美国的试管婴儿技术相对于国内三甲医院是否更先进呢?在本文中,我们将详细介绍美国与国内三甲医院之间的试管婴儿技术差异。
美国作为全球试管婴儿技术的领先者之一,拥有许多专业且经验丰富的试管医院。这些机构配备了比较新的设备和先进的科学研究支持,并且拥有经过专业培训的医疗团队,助孕括生殖内分泌学家、胚胎学家、遗传学家等。
国内也有许多优秀的三甲医院提供试管婴儿技术,并且在该领域取得了长足发展。以下是国内三甲医院试管婴儿技术的特点:
| 特点 | 介绍 |
|---|---|
| 1.大规模试管医院 | 国内三甲医院拥有大规模的试管医院,可以同时处理多个患者的需求。这使得医院能够更高效地进行试管婴儿技术操作。 |
| 2.价格相对较低 | 相比于美国,国内三甲医院的试管婴儿技术价格相对较低,这也吸引了一些外国患者前来接受治疗。 |
| 3.不断创新进步 | 国内的试管医院领域不断创新进步,不仅在技术上有所突破,还在法律和政策层面提供了更好的支持。 |
虽然美国和国内三甲医院在试管婴儿技术方面都取得了显着进展,但仍存在一些区别:
美国和国内三甲医院在试管婴儿技术方面都有各自的优势。美国拥有先进的设备、个性化治疗和创新科研,而国内三甲医院则具备大规模试管医院和较低价格等特点。无论选择哪种地区进行试管婴儿技术,重要的是根据个人情况选择适合自己的医院,并与专业团队进行充分沟通和讨论。
以上就是医院招聘网小编为大家整理的《美国试管婴儿技术和国内三甲医院相比,哪个更好》相关信息,希望大家喜欢。
内容版权声明:本网站部分内容由网上整理转发,如有侵权请联系管理员进行删除.